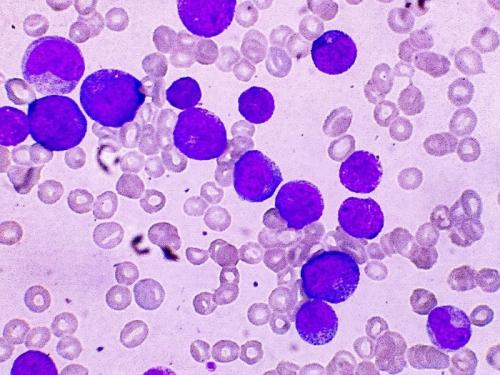

-
41 %
of cancers in children aged 0-14 are leukaemias or lymphomas
-
1 in 5
young people aged 15-24 do not survive for more than 5 years after diagnosis of leukaemia
-
3 in 10
cancers diagnosed in children aged 0-14 are leukaemias
While overall survival rates for blood cancer are higher than other types of cancers diagnosed in these age groups, further research is needed to find kinder, more effective treatments, especially for less-common subtypes of blood cancer which tend to have poorer outcomes.
Funds raised by the CCLG Blood Cancer Research Fund will support world-leading research projects investigating leukaemia and lymphoma, changing the future for children and young people with cancer.

Donate today
You can support world-leading research projects investigating leukaemia and lymphoma